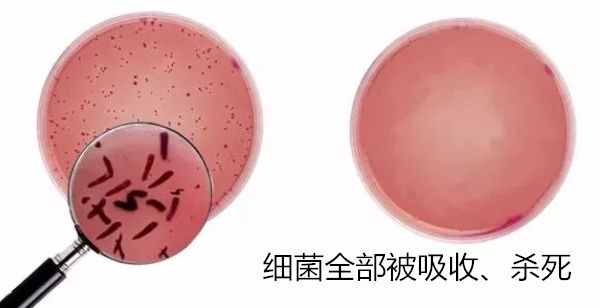
冰箱有异味放什么除菌,冰箱有异味能清出来嘛

大家生活中经常会遇到这个问题:冰箱里面东西太多了,来不及整理,放的时间久了,剩菜和腐烂的水果混在一起。
那个味道想想就很臭!

放个面包进去,第二天全是冰箱的怪味,咬起来全是恶心的冰箱味......

不止是异味的问题,蔬菜、肉五花八门,腐烂到一起产生的细菌才是最让人担心的。

全球卫生理事协会发布的《家庭卫生报告》显示:

你的冰箱不再是美食保险箱,而成了个“细菌窝”。
食物在里面腐败变质,那可是会危害健康的呀

有了宝宝或孕妇家庭要关注,这可能会危害到孩子健康!
号称“冰箱杀手”的李斯特菌,生命力极其顽强,在0-45℃都能生存。
人体一旦感染,轻则急性肠胃炎、发烧、拉肚子,重则脑膜炎、败血症,甚至还会导致胎死腹中!

曾经何时,我们为了新鲜的食物、健康的身体,也曾修炼过冰箱除味*法大**,可效果却并不如人意。

直到我在日本留学的朋友告诉我,日本的家庭主妇为了避免冰箱异味,都会在冰箱里放置除臭蛋。
除臭蛋吸异味的同时,还能吸附冰箱空气里的脏东西,防止细菌产生。
后来她把那个除臭蛋推荐给了我,我试用了一段时间,冰箱真的没那么臭了!放的面包,第二天依然是淡淡的奶香味。
必须推荐给大家!

【滚蛋吧 异味】
冰箱除味剂除味盒
非除异味家用去味除臭活性炭包
原价¥49
(花田严选活动价¥39.9)
【拍一发三】
点击购买
关注微信公众号“花田严选”查询订单、物流

它的除臭效果有多好呢?我给大家做个实验。
在一个满满都是尘雾的瓶子里,放上我们的除臭蛋。不到一个小时,里面的灰尘和水汽都被吸得干干净净的!

一个蛋的除臭能力,约等于500包活性炭。
硅藻土+活性炭+水晶矿物,三管齐下,去异味效果,比传统竹炭包好用哦!

同时,它的除臭能力也获得正规检测机构认证,禾川化学检测机构的分析报告显示:
拥有环境除臭、去异味的功效
将除味蛋放置冰箱一周, 冰箱无串味,无异味,还可延长蔬果保鲜时长。

我送了一个除味蛋给设计师小姐姐,她是个东北人,爱吃辣白菜、腊八蒜等重口味的东西,冰箱常常有一股味道。
放了几天后,回来跟我说,你那个除味蛋真的太神奇了。现在我冰箱啥味都没有!真后悔没早点知道。

【滚蛋吧 异味】
冰箱除味剂除味盒
非除异味家用去味除臭活性炭包
原价¥49
(花田严选活动价¥39.9)
【拍一发三】
点击购买
关注微信公众号“花田严选”查询订单、物流

一般的除味蛋只有两种吸附原料,而这款,采用3种吸附原料:深海硅藻土+活性炭+纳米水晶矿石,吸附能力更强劲。

硅藻土是一种硅质岩石,具有多孔和速干特性。能快速吸附烟尘和水分,从而达到除臭吸味、抗菌防毒、净化空气的效果。

再潮湿的环境,放入硅藻土,也能迅速除湿,去异味。来看下它的吸附能力有多强:

一个除臭蛋中还含有500个活性炭,活性炭能吸附空气中的微小颗粒,让空气迅速洁净起来。

再也不用忍受一打开就异味熏天的冰箱,所有味道和细菌都被吸收,细菌减少,食物腐烂速度自然降低!冰箱重头变得卫生干净!
消除冰箱的细菌可不是简单的事,于是小编拿家里的生肉做了对比,没有放除臭蛋的4天就坏了,但是放了除臭蛋的居然一个星期还是新鲜的。

不仅除臭杀菌,还能让食物的新鲜度延长3倍买食材的钱都省了一大半。
【滚蛋吧 异味】
冰箱除味剂除味盒
非除异味家用去味除臭活性炭包
原价¥49
(花田严选活动价¥39.9)
【拍一发三】
点击购买
关注微信公众号“花田严选”查询订单、物流

这款除味蛋我是买给我妈的。平时我买啥东西给我妈,我妈要不嫌不好用,要不嫌贵。只有这东西,她用了一段时间后,激动得的打电话给我说要我再给她买一些!
不仅是自己用过很好,我看网上买过这个除味蛋的,好评也多多。

【滚蛋吧 异味】
冰箱除味剂除味盒
非除异味家用去味除臭活性炭包
原价¥49
(花田严选活动价¥39.9)
【拍一发三】
点击购买
关注微信公众号“花田严选”查询订单、物流

更令我满意的是,这款除味蛋,并不是只有冰箱可用。哪里有臭味哪里潮湿就放在哪里!
冰箱去异味

衣柜里除湿去霉

各种平时密封的储物柜,也可以放

还可以除鞋的脚臭味

最潮湿的卫生间当然要多放几颗,强力祛湿,去异味!

一个除味蛋能用三个月。当然,要是冰箱异味实在太大了,还是要勤点更换。
真心推荐大家买~
有孩子的家庭,为了小孩的健康,放个除味蛋在冰箱,有利无害。
上班的白领,经常没空整理冰箱,冰箱有异味时有发生,放个这,也不用再担心。
现在正好有优惠,原价49元的除味蛋,现在搞活动,39元/3个,拍一发三。价格很划算,哪里都能用到。建议大家多拍些,以备不时之需~
【滚蛋吧 异味】
冰箱除味剂除味盒
非除异味家用去味除臭活性炭包
原价¥49
(花田严选活动价¥39.9)
【拍一发三】
点击购买
